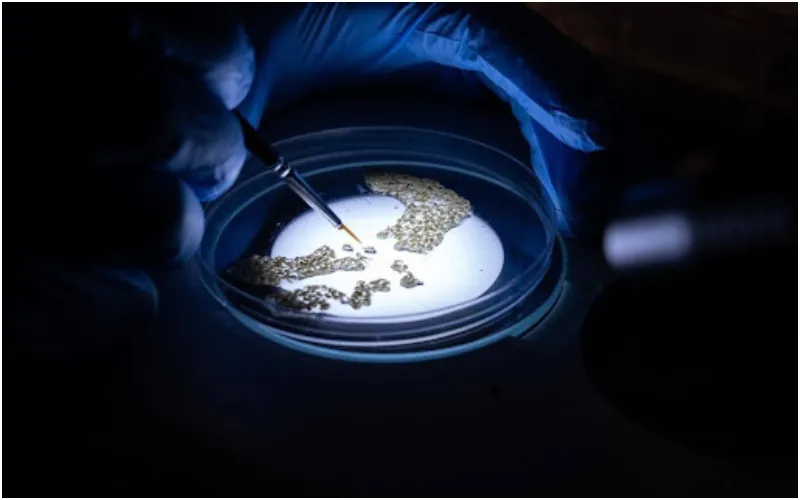
Mosquito larvae are screened in a Petri dish in the lab. Photo credit : Target Malaria.

KAMPALA, Uganda – As the world marks World Malaria Day, scientists across Africa are exploring new ways to reduce the spread of one of the continent’s deadliest diseases: malaria.
While significant progress has been made over the past two decades, the 2025 Africa Malaria Progress Report warns that momentum in the fight against malaria has stalled.
Despite continued efforts, Africa remains off track to meet the African Union’s target of eliminating malaria by 2030, with progress slowing since 2015 and only a handful of countries reaching key reduction milestones.
At the same time, a widening global funding gap, combined with growing challenges such as insecticide resistance, climate pressures and fragile health systems, has raised concerns that malaria could resurge if sustained investment and innovation are not prioritised.
This means researchers need to study complementary approaches that could strengthen malaria prevention to save lives. Among these is gene drive technology, a genetic approach that scientists are investigating as a possible innovation that could complement existing interventions, such as bed nets, insecticides, drugs and vaccines.
Targeting the mosquitoes that spread malaria
Out of more than 3,500 mosquito species worldwide, only a small number transmit malaria. In sub-Saharan Africa, just a few closely related mosquito species are responsible for most of the transmission.
Scientists from Target Malaria are exploring whether gene drive technology could help reduce populations of these malaria-carrying mosquitoes or stop the parasite from being passed on from mosquito to human.
How scientists develop gene drive mosquitoes
Developing gene drive mosquitoes is a long and meticulous process that begins in highly controlled laboratory environments. Researchers design genetic modifications and carefully introduce them into mosquito embryos using extremely fine needles under microscopes.
The process must be done shortly after mosquito eggs are laid, when the embryos are at the right stage of development.
Only a few researchers in the world have this know-how. Because the procedure is delicate, not all modified embryos will produce modified mosquitoes; sometimes the genetic modification does not succeed.
Scientists then identify which mosquitoes successfully carry the genetic modification and establish laboratory colonies to continue studying the trait over multiple generations. These colonies allow researchers to observe how the modification is passed on and whether it is inherited at expected rates.
Testing safety and efficacy
Once a colony has been established, scientists carry out extensive laboratory testing to study how the mosquitoes behave and how the modification spreads.
Initial studies take place in small laboratory cages, where researchers observe how gene drive mosquitoes interact and reproduce with wild mosquitoes of the same species.
Further testing is then conducted in larger indoor environments designed to mimic natural conditions, allowing scientists to better understand how the modification might behave outside the laboratory.
Researchers also study important factors such as mosquito lifespan, biting behaviour, disease transmission potential, and resistance to insecticides, comparing gene drive mosquitoes to their wild counterparts.
Mathematical modelling is used alongside laboratory studies to predict how the modification might spread through mosquito populations and what impact it could have on malaria transmission.
“Innovation and investment are essential in the fight against malaria, but so is transparency. People must understand how new technologies are researched, assessed and tested before they are ever considered for use,” says Dr Martin Lukindu, Post-Doctoral Research Associate, Target Malaria Uganda, Uganda Virus Research Institute (UVRI).
A long road before any real-world use
Gene drive mosquitoes are still in the research phase, and all studies are currently conducted in contained laboratories in Europe and the United States. There are no gene drive mosquitoes in Africa.
Before any future use could be considered, extensive safety studies must be completed, followed by regulatory review in the countries where research would take place. Engagement with communities and agreement from relevant authorities would also be required.
“As scientists, our goal remains the same: reduce malaria transmission and save African lives,” says Dr. Lukindu.








Discussion about this post